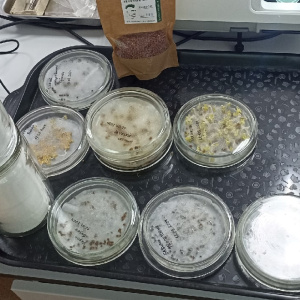

Воспитанники объединения "Агрономик" приняли участие в мастер-классе на базе Сургутского государственного университета
15 марта восемь воспитанников объединения "Агрономик" Центра дополнительного образования, совместно с руководителем объединения Захаровой Яной Валерьевной, приняли участие в мастер-классе "Методы анализа и обработки посевного материала" на базе Сургутского государственного университета.
Данное мероприятие являются частью региональной сетевой программы "Инженерные биологические системы" и направлен на приобретение школьниками компетенций, необходимых для участия в Национальной технологической Олимпиаде.
В процессе мастер-класса, ребята провели фитопотологическую экспертизу семян, определили всхожесть семян, провели предпосевную обработку семян, провели посев семян на бумажную ленту. Такие мероприятия закладывают практические основы биологических знаний у ребят и ориентируют их на выбор будущей профессии, биологического профиля.